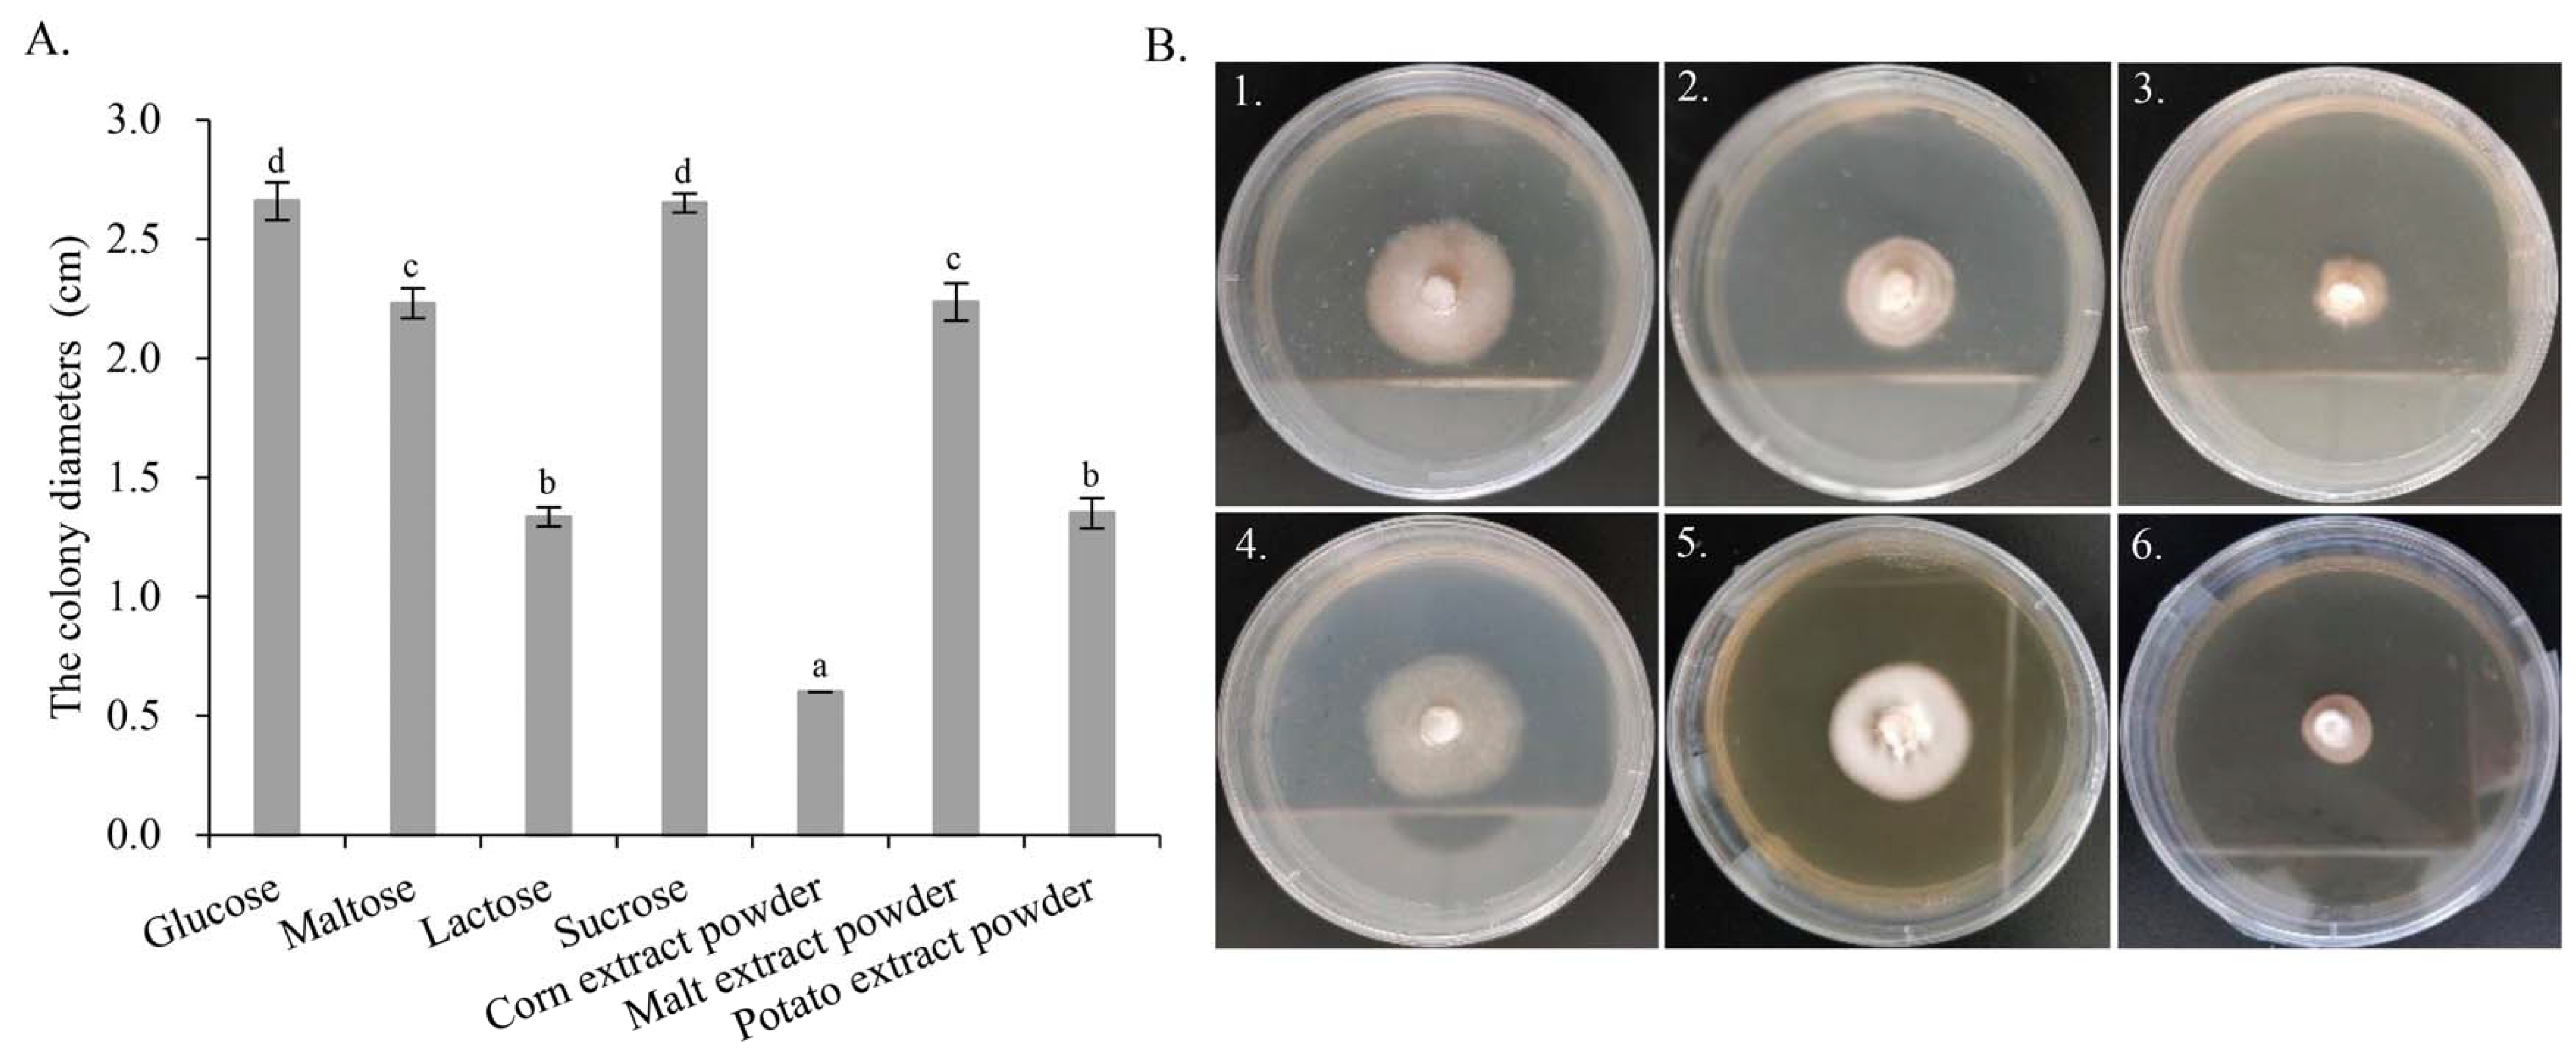
Genes 13 01628 g007 Genes 13 01628 g007

Whole-Genome Sequencing and Comparative Genomics Analysis of the Wild Edible Mushroom (Gomphus purpuraceus) Provide Insights into Its Potential Food Application and Artificial Domestication
Abstract
1. Introduction
2. Materials and Methods
2.1. Fungal Strains
2.2. Library Construction, Sequencing and Assembly
2.3. Genomic Prediction and Genome Annotation
2.4. Comparative Genomics Analysis
2.5. Optimization of Culture Medium for G. purpuraceus
3. Results
3.1. Analysis of the Genome Assembly and Gene Prediction
3.2. Gene General Annotation
3.3. Gene Special Annotation
3.4. Comparative Genomics Analysis
3.4.1. Gene Family Analysis
3.4.2. Phylogenetic Relationship of G. purpuraceus
3.4.3. Comparative Analysis of CAZymes
3.4.4. Comparative Analysis of Secondary Metabolisms
3.5. Optimization of Culture Medium
4. Discussion
5. Conclusions
Supplementary Materials
Author Contributions
Funding
Institutional Review Board Statement
Informed Consent Statement
Data Availability Statement
Conflicts of Interest
References
- Li, H.; Tian, Y.; Menolli, N.; Ye, L.; Karunarathna, S.C.; Perez-Moreno, J.; Rahman, M.M.; Rashid, H.; Phengsintham, P.; Rizal, L.; et al. Reviewing the world’s edible mushroom species: A new evidence-based classification system. Compr. Rev. Food. Sci. Food Saf. 2021, 20, 1982–2014. [Google Scholar] [CrossRef] [PubMed]
- Xun, W.; Wang, G.; Zhang, Y.; Liao, G.; Ge, C. Analysis of flavor-related compounds in four edible wild mushroom soups. Microchem. J. 2020, 159, 105548. [Google Scholar] [CrossRef]
- Jacinto-Azevedo, B.; Valderrama, N.; Henríquez, K.; Aranda, M.; Aqueveque, P. Nutritional value and biological properties of Chilean wild and commercial edible mushrooms. Food Chem. 2021, 356, 129651. [Google Scholar] [CrossRef] [PubMed]
- De Silva, D.D.; Rapior, S.; Sudarman, E.; Stadler, M.; Xu, J.; Alias, S.A.; Hyde, K.D. Bioactive metabolites from macrofungi: Ethnopharmacology, biological activities and chemistry. Fungal Divers. 2013, 62, 1–40. [Google Scholar] [CrossRef]
- Wu, F.; Zhou, L.-W.; Yang, Z.-L.; Bau, T.; Li, T.-H.; Dai, Y.-C. Resource diversity of Chinese macrofungi: Edible, medicinal and poisonous species. Fungal Divers. 2019, 98, 1–76. [Google Scholar] [CrossRef]
- Zhang, J.X.; Chen, Q.; Huang, C.Y.; Gao, W.; Qu, J. History, current situation and trend of edible mushroom industry development. Mycosystema 2015, 34, 524–540. (In Chinese) [Google Scholar] [CrossRef]
- Agerer, R. Descriptions of ectomycorrhizae. Mycologist 1996, 16, 83–84. [Google Scholar] [CrossRef]
- Giachini, A.J.; Castellano, M.A. A new taxonomic classification for species in Gomphus sensu lato. Mycotaxon 2011, 115, 183–201. [Google Scholar] [CrossRef]
- Cantrell, C.L.; Case, B.P.; Mena, E.E.; Kniffin, T.M.; Duke, S.O.; Wedge, D.E. Isolation and identification of antifungal fatty acids from the basidiomycete Gomphus floccosus. J. Agric. Food Chem. 2008, 56, 5062–5068. [Google Scholar] [CrossRef]
- Lamus, V.; Franco, S.; Montoya, L.; Endara, A.R.; Caballero, L.A.; Bandala, V. Mycorrhizal synthesis of the edible mushroom Turbinellus floccosus with Abies religiosa from central Mexico. Mycoscience 2015, 56, 622–626. [Google Scholar] [CrossRef]
- Jiang, M.-Y.; Yang, X.-L.; Fang, L.-Z.; Zhang, L.; Dong, Z.-J.; Liu, J.-K. Purpuracolide: A new alliacane sesquiterpene from the basidiomycete Gomphus purpuraceus. Z. Naturforsch. B 2008, 63, 1012–1014. [Google Scholar] [CrossRef]
- He, Y.; Wan, Y.; Zhou, Y.; Cai, X.; Guo, Z.; Hu, F.; Qin, Y.; Tan, A.; Deng, Z. Two new alliacane sesquiterpenes from the fruiting bodies of edible mushroom Gomphus purpuraceus. Phytochem. Lett. 2022, 50, 85–88. [Google Scholar] [CrossRef]
- Grayer, R.J.; Thabrew, M.I.; Hughes, R.D.; Bretherton, S.; Lever, A.; Veitch, N.C.; Kite, G.C.; Lelli, R.; Simmonds, M.S. Phenolic and terpenoid constituents from the SriLankan medicinal plant Osbeckia aspera. Pharm. Biol. 2008, 46, 154–161. [Google Scholar] [CrossRef][Green Version]
- Ulubelen, A.; Öksüz, S.; Kolak, U.; Birman, H.; Voelter, W. Cardioactive terpenoids and a new rearranged diterpene from Salvia syriaca. Planta Med. 2000, 66, 627–629. [Google Scholar] [CrossRef] [PubMed]
- Xia, Q.; Zhang, H.; Sun, X.; Zhao, H.; Wu, L.; Zhu, D.; Yang, G.; Shao, Y.; Zhang, X.; Mao, X.; et al. A comprehensive review of the structure elucidation and biological activity of triterpenoids from Ganoderma spp. Molecules 2014, 19, 17478–17535. [Google Scholar] [CrossRef]
- Kupka, J.; Anke, T.; Giannetti, B.-M.; Steglich, W. Antibiotics from basidiomycetes. Arch. Microbiol. 1981, 130, 223–227. [Google Scholar] [CrossRef]
- Sharma, S.H.; Thulasingam, S.; Nagarajan, S. Terpenoids as anti-colon cancer agents-A comprehensive review on its mechanistic perspectives. Eur. J. Pharmacol. 2017, 795, 169–178. [Google Scholar] [CrossRef]
- Tedersoo, L.; May, T.W.; Smith, M.E. Ectomycorrhizal lifestyle in fungi: Global diversity, distribution, and evolution of phylogenetic lineages. Mycorrhiza 2010, 20, 217–263. [Google Scholar] [CrossRef]
- Tan, A.H.; Liu, F.Z. First report of the characteristic form and growing up environment of Gomphus purpuraceus. Edible Fungi. China. 2002, 21, 6–7. (In Chinese) [Google Scholar] [CrossRef]
- Floudas, D.; Binder, M.; Riley, R.; Barry, K.; Blanchette, R.A.; Henrissat, B.; Martínez, A.T.; Otillar, R.; Spatafora, J.W.; Yadav, J.S.; et al. The Paleozoic origin of enzymatic lignin decomposition reconstructed from 31 fungal genomes. Science 2012, 336, 1715–1719. [Google Scholar] [CrossRef]
- Floudas, D.; Held, B.W.; Riley, R.; Nagy, L.G.; Koehler, G.; Ransdell, A.S.; Younus, H.; Chow, J.; Chiniquy, J.; Lipzen, A.; et al. Evolution of novel wood decay mechanisms in Agaricales revealed by the genome sequences of Fistulina hepatica and Cylindrobasidium torrendii. Fungal Genet. Biol. 2015, 76, 78–92. [Google Scholar] [CrossRef] [PubMed]
- Nagy, L.G.; Riley, R.; Tritt, A.; Adam, C.; Daum, C.; Floudas, D.; Sun, H.; Yadav, J.S.; Pangilinan, J.; Larsson, K.-H.; et al. Comparative genomics of early-diverging mushroom-forming fungi provides insights into the origins of lignocellulose decay capabilities. Mol. Biol. Evol. 2016, 33, 959–970. [Google Scholar] [CrossRef] [PubMed]
- Almási, É.; Sahu, N.; Krizsán, K.; Balint, B.; Kovács, G.M.; Kiss, B.; Cseklye, J.; Drula, E.; Henrissat, B.; Nagy, I.; et al. Comparative genomics reveals unique wood-decay strategies and fruiting body development in the Schizophyllaceae. New Phytol. 2019, 224, 902–915. [Google Scholar] [CrossRef]
- Baldrian, P. Enzymes of saprotrophic basidiomycetes. Br. Mycol. Soc. Symp. 2008, 28, 19–41. [Google Scholar] [CrossRef]
- Martinez, D.; Challacombe, J.; Morgenstern, I.; Hibbett, D.; Schmoll, M.; Kubicek, C.P.; Ferreira, P.; Ruiz-Duenas, F.J.; Martinez, A.T.; Kersten, P.; et al. Genome, transcriptome, and secretome analysis of wood decay fungus Postia placenta supports unique mechanisms of lignocellulose conversion. Proc. Natl. Acad. Sci. USA 2009, 106, 1954–1959. [Google Scholar] [CrossRef] [PubMed]
- Eastwood, D.C.; Floudas, D.; Binder, M.; Majcherczyk, A.; Schneider, P.; Aerts, A.; Asiegbu, F.O.; Baker, S.E.; Barry, K.; Bendiksby, M.; et al. The plant cell wall-decomposing machinery underlies the functional diversity of forest fungi. Science 2011, 333, 762–765. [Google Scholar] [CrossRef] [PubMed]
- Boraston, A.B.; Bolam, D.; Gilbert, H.J.; Davies, G. Carbohydrate-binding modules: Fine-tuning polysaccharide recognition. Biochem. J. 2004, 382, 769–781. [Google Scholar] [CrossRef] [PubMed]
- Kohler, A.; Kuo, A.; Nagy, L.G.; Morin, E.; Barry, K.W.; Buscot, F.; Canbäck, B.; Choi, C.; Cichocki, N.; Clum, A.; et al. Convergent losses of decay mechanisms and rapid turnover of symbiosis genes in mycorrhizal mutualists. Nat. Genet. 2015, 47, 410–415. [Google Scholar] [CrossRef]
- Shah, F.; Nicolás, C.; Bentzer, J.; Ellström, M.; Smits, M.M.; Rineau, F.; Canbäck, B.; Floudas, D.; Carleer, R.; Lackner, G.; et al. Ectomycorrhizal fungi decompose soil organic matter using oxidative mechanisms adapted from saprotrophic ancestors. New Phytol. 2016, 209, 1705–1719. [Google Scholar] [CrossRef]
- Kropp, B.R. Fungi from decayed wood as ectomycorrhizal symbionts of western hemlock. Can. J. For. Res. 1982, 21, 36–39. [Google Scholar] [CrossRef]
- Roberts, C.; Ceska, O.; Kroeger, P.; Kendrick, B. Macrofungi from six habitats over five years in Clayoquot Sound, Vancouver Island. Can. J. Bot. 2004, 82, 1518–1538. [Google Scholar] [CrossRef]
- Lõster, H.; Punzel, M. Systematics of pleurotoid Russulaceae from Guyana and Japan, with notes on their ectomycorrhizal status. Mycologia 2000, 92, 1119–1132. [Google Scholar] [CrossRef]
- Miyauchi, S.; Kiss, E.; Kuo, A.; Drula, E.; Kohler, A.; Sánchez-García, M.; Morin, E.; Andreopoulos, B.; Barry, K.W.; Bonito, G.; et al. Large-scale genome sequencing of mycorrhizal fungi provides insights into the early evolution of symbiotic traits. Nat. Commun. 2020, 11, 5125. [Google Scholar] [CrossRef] [PubMed]
- Looney, B.P.; Meidl, P.; Piatek, M.J.; Miettinen, O.; Martin, F.M.; Matheny, P.B.; Labbé, J.L. Russulaceae: A new genomic dataset to study ecosystem function and evolutionary diversification of ectomycorrhizal fungi with their tree associates. New Phytol. 2018, 218, 54–65. [Google Scholar] [CrossRef] [PubMed]
- Plettm, J.M.; Martin, F. Blurred boundaries: Lifestyle lessons from ectomycorrhizal fungal genomes. Trends Genet. 2011, 27, 14–22. [Google Scholar] [CrossRef]
- Cali, D.S.; Kim, J.S.; Ghose, S.; Alkan, C.; Mutlu, O. Nanopore sequencing technology and tools for genome assembly: Computational analysis of the current state, bottlenecks and future directions. Brief. Bioinform. 2019, 20, 1542–1559. [Google Scholar] [CrossRef]
- Marçais, G.; Kingsford, C. A fast, lock-free approach for efficient parallel counting of occurrences of k-mers. Bioinformatics 2011, 27, 764–770. [Google Scholar] [CrossRef]
- Koren, S.; Walenz, B.P.; Berlin, K.; Miller, J.R.; Bergman, N.H.; Phillippy, A.M. Canu: Scalable and accurate long-read assembly via adaptive k-mer weighting and repeat separation. Genome Res. 2017, 27, 722–736. [Google Scholar] [CrossRef]
- Ruan, J.; Li, H. Fast and accurate long-read assembly with wtdbg2. Nat. Methods. 2020, 17, 155–158. [Google Scholar] [CrossRef]
- Walker, B.J.; Abeel, T.; Shea, T.; Priest, M.; Abouelliel, A.; Sakthikumar, S.; Cuomo, C.A.; Zeng, Q.; Wortman, J.; Young, S.K.; et al. Pilon: An integrated tool for comprehensive microbial variant detection and genome assembly improvement. PLoS ONE 2014, 9, e112963. [Google Scholar] [CrossRef]
- Li, H.; Durbin, R. Fast and accurate short read alignment with Burrows-Wheeler transform. Bioinformatics 2009, 25, 1754–1760. [Google Scholar] [CrossRef] [PubMed]
- Simão, F.A.; Waterhouse, R.M.; Ioannidis, P.; Kriventseva, E.V.; Zdobnov, E.M. BUSCO: Assessing genome assembly and annotation completeness with single-copy orthologs. Bioinformatics 2015, 31, 3210–3212. [Google Scholar] [CrossRef] [PubMed]
- Chen, N.S. Using repeatmasker to identify repetitive elements in genomic sequences. Curr. Protoc. Bioinform. 2004, 4, 4–10. [Google Scholar] [CrossRef]
- Lowe, T.M.; Eddy, S.R. tRNAscan-SE: A Program for Improved Detection of Transfer RNA Genes in Genomic Sequence. Nucleic Acids Res. 1997, 25, 955–964. [Google Scholar] [CrossRef]
- Nawrocki, E.P.; Eddy, S.R. Infernal 1.1: 100-fold faster RNA homology searches. Bioinformatics 2013, 29, 2933–2935. [Google Scholar] [CrossRef]
- Awrocki, E.P.; Burge, S.W.; Bateman, A.; Daub, J.; Eberhardt, R.; Eddy, S.; Floden, E.; Gardner, P.P.; Jones, T.A.; Tate, J.; et al. Rfam 12.0: Updates to the RNA families database. Nucleic Acids Res. 2014, 43, 130–137. [Google Scholar] [CrossRef]
- Birney, E.; Clamp, M.; Durbin, R. GeneWise and Genomewise. Genome Res. 2004, 14, 988–995. [Google Scholar] [CrossRef]
- Blin, K.; Shaw, S.; Kloosterman, A.M.; Charlop-Powers, Z.; van Wezel, G.P.; Medema, M.H.; Weber, T. antiSMASH 6.0: Improving cluster detection and comparison capabilities. Nucleic Acids Res. 2021, 49, W29–W35. [Google Scholar] [CrossRef]
- Boeckmann, B. The SWISS-PROT protein knowledgebase and its supplement TrEMBL in 2003. Nucleic Acids Res. 2003, 31, 365–370. [Google Scholar] [CrossRef]
- Conesa, A.; Götz, S.; García-Gómez, J.M.; Terol, J.; Talón, M.; Robles, M. Blast2GO: A universal tool for annotation, visualization and analysis in functional genomics research. Bioinformatics 2005, 21, 3674–3676. [Google Scholar] [CrossRef]
- Eddy, S.R. Profile hidden Markov models. Bioinformatics 1998, 14, 755–763. [Google Scholar] [CrossRef] [PubMed]
- Foulongne-Oriol, M.; Taskent, O.; Kües, U.; Sonnenberg, A.; van Peer, A.; Giraud, T. Mating-type locus organization and mating-type chromosome differentiation in the bipolar edible button mushroom Agaricus Bisporus. Genes 2021, 12, 1079. [Google Scholar] [CrossRef] [PubMed]
- Martin, F.; Aerts, A.; Ahrén, D.; Brun, A.; Danchin, E.G.J.; Duchaussoy, F.; Gibon, J.; Kohler, A.; Lindquist, E.; Pereda, V.; et al. The genome of Laccaria bicolor provides insights into mycorrhizal symbiosis. Nature 2008, 452, 88–92. [Google Scholar] [CrossRef]
- Li, H.; Wu, S.; Ma, X.; Chen, W.; Zhang, J.; Duan, S.; Gao, Y.; Kui, L.; Huang, W.; Wu, P.; et al. The Genome Sequences of 90 Mushrooms. Sci. Rep. 2018, 8, 9982. [Google Scholar] [CrossRef] [PubMed]
- Yu, F.; Song, J.; Liang, J.; Wang, S.; Lu, J. Whole genome sequencing and genome annotation of the wild edible mushroom, Russula griseocarnosa. Genomics 2020, 112, 603–614. [Google Scholar] [CrossRef]
- Martin, F.; Kohler, A.; Murat, C.; Balestrini, R.; Coutinho, P.M.; Jaillon, O.; Montanini, B.; Morin, E.; Noel, B.; Percudani, R.; et al. Périgord black truffle genome uncovers evolutionary origins and mechanisms of symbiosis. Nature 2010, 464, 1033–1038. [Google Scholar] [CrossRef]
- Gong, W.-B.; Li, L.; Zhou, Y.; Bian, Y.-B.; Kwan, H.-S.; Cheung, M.-K.; Xiao, Y. Genetic dissection of fruiting body-related traits using quantitative trait loci mapping in Lentinula edodes. Appl. Microbiol. Biotechnol. 2016, 100, 5437–5452. [Google Scholar] [CrossRef]
- Park, Y.-J.; Baek, J.H.; Lee, S.; Kim, C.; Rhee, H.; Kim, H.; Seo, J.-S.; Park, H.-R.; Yoon, D.-E.; Nam, J.-Y.; et al. Whole genome and global gene expression analyses of the model mushroom Flammulina velutipes reveal a high capacity for lignocellulose degradation. PLoS ONE 2014, 9, e93560. [Google Scholar] [CrossRef] [PubMed]
- Qu, J.; Zhao, M.; Hsiang, T.; Feng, X.; Zhang, J.; Huang, C. Identification and characterization of small noncoding RNAs in genome sequences of the edible fungus Pleurotus ostreatus. BioMed Res. Int. 2016, 7, 2503023. [Google Scholar] [CrossRef]
- Liu, W.; Chen, L.; Cai, Y.; Zhang, Q.; Bian, Y. Opposite polarity monospore genome de novo sequencing and comparative analysis reveal the possible heterothallic life cycle of Morchella importuna. Int. J. Mol. Sci. 2018, 19, 2525. [Google Scholar] [CrossRef]
- Cao, Y.; Zhang, Y.; Yu, Z.; Wang, P.; Tang, X.; He, X.; Mi, F.; Liu, C.; Yang, D.; Xu, J. Genome sequence of Phlebopus portentosus strain PP33, a cultivated Bolete. Genome Announc. 2015, 3, e00326-15. [Google Scholar] [CrossRef]
- Kumla, J.; Hobbie, E.A.; Suwannarach, N.; Lumyong, S. The ectomycorrhizal status of a tropical black bolete, Phlebopus portentosus, assessed using mycorrhizal synthesis and isotopic analysis. Mycorrhiza 2016, 26, 333–343. [Google Scholar] [CrossRef] [PubMed]
- Eddy, S.R. A new generation of homology search tools based on probabilistic inference. Genome Inf. 2009, 23, 205–211. [Google Scholar] [CrossRef]
- Gu, C.B.; Jiang, L.L.; Wang, K.Y.; Shi, X.B.; Duan, H.M.; Lin, C.H. Induction and Characteristics of Fusarium oxysporum f. sp. fragariae ZY-W Resistant to Tebuconazole. Sci. Agric. Sin. 2010, 43, 2897–2904. [Google Scholar] [CrossRef]
- Kang, H.; Chen, X.; Kemppainen, M.; Pardo, A.G.; Veneault-Fourrey, C.; Kohler, A.; Martin, F.M. The small secreted effector protein MiSSP7.6 of Laccaria bicolor is required for the establishment of ectomycorrhizal symbiosis. Environ. Microbiol. 2020, 22, 1435–1446. [Google Scholar] [CrossRef]
- Plett, J.M.; Kemppainen, M.; Kale, S.D.; Kohler, A.; Legué, V.; Brun, A.; Tyler, B.M.; Pardo, A.G.; Martin, F. A secreted effector protein of Laccaria bicolor is required for symbiosis development. Curr. Biol. 2011, 21, 1197–1203. [Google Scholar] [CrossRef] [PubMed]
- Pellegrin, C.; Daguerre, Y.; Ruytinx, J.; Guinet, F.; Kemppainen, M.; Frey, N.F.D.; Puech-Pagès, V.; Hecker, A.; Pardo, A.G.; Martin, F.M.; et al. Laccaria bicolor MiSSP8 is a small-secreted protein decisive for the establishment of the ectomycorrhizal symbiosis. Environ. Microbiol. 2019, 21, 3765–3779. [Google Scholar] [CrossRef]
- Kojima, Y.; Várnai, A.; Eijsink, V.G.H.; Yoshida, M. The Role of Lytic Polysaccharide Monooxygenases in Wood Rotting Basidiomycetes, Trends Glycosci. Glycotechnol 2020, 32, 135–143. [Google Scholar] [CrossRef]
- Bödeker, I.T.M.; Nygren, C.M.R.; Taylor, A.F.S.; Lindahl, B.D. ClassII peroxidase-encoding genes are present in a phylogenetically wide range of ectomycorrhizal fungi. ISME J. 2009, 3, 1387–1395. [Google Scholar] [CrossRef]
- Wan, J.-N.; Li, Y.; Guo, T.; Ji, G.-Y.; Luo, S.-Z.; Ji, K.-P.; Cao, Y.; Tan, Q.; Bao, D.-P.; Yang, R.-H. Whole-genome and transcriptome sequencing of Phlebopus portentosus reveals its associated ectomycorrhizal niche and conserved pathways involved in fruiting body development. Front. Microbiol. 2021, 12, 732458. [Google Scholar] [CrossRef]
- Agger, S.; Lopez-Gallego, F.; Schmidt-Dannert, C. Diversity of sesquiterpene synthases in the basidiomycete Coprinus cinereus. Mol. Microbiol. 2009, 72, 1181–1195. [Google Scholar] [CrossRef] [PubMed]
- Wawrzyn, G.T.; Held, M.A.; Bloch, S.E.; Schmidt-Dannert, C. Genome mining for fungal secondary metabolic gene clusters. In Biosynthesis and Molecular Genetics of Fungal Secondary Metabolites; Springer: New York, NY, USA, 2015; Volume 2, pp. 43–65. [Google Scholar] [CrossRef]
- Quin, M.B.; Flynn, C.M.; Schmidtdannert, C. Traversing the fungal terpenome. Nat. Prod. Rep. 2014, 31, 1449–1473. [Google Scholar] [CrossRef] [PubMed]
- Ditengou, F.A.; Müller, A.; Rosenkranz, M.; Felten, J.; Lasok, H.; Van Doorn, M.M.; Legué, V.; Palme, K.; Schnitzler, J.-P.; Polle, A. Volatile signalling by sesquiterpenes from ectomycorrhizal fungi reprogrammes root architecture. Nat. Commun. 2015, 6, 6279. [Google Scholar] [CrossRef] [PubMed]
- Yap, H.-Y.Y.; Chooi, Y.-H.; Firdaus-Raih, M.; Fung, S.-Y.; Ng, S.-T.; Tan, C.-S.; Tan, N.-H. The genome of the tiger milk mushroom, Lignosus rhinocerotis, provides insights into the genetic basis of its medicinal properties. BMC Genom. 2014, 15, 635. [Google Scholar] [CrossRef]
- Yoder, O.C.; Turgeon, B.G. Fungal genomics and pathogenicity. Curr. Opin. Struct. Biol. 2001, 4, 315–321. [Google Scholar] [CrossRef]
- Wymelenberg, A.V.; Gaskell, J.; Mozuch, M.; Sabat, G.; Ralph, J.; Skyba, O.; Mansfield, S.D.; Blanchette, R.A.; Martinez, D.; Grigoriev, I.; et al. Comparative transcriptome and secretome analysis of wood decay fungi Postia placenta and Phanerochaete chrysosporium. Appl. Environ. Microbiol. 2010, 76, 3599–3610. [Google Scholar] [CrossRef]
- Yelle, D.J.; Ralph, J.; Lu, F.; Hammel, K.E. Evidence for cleavage of lignin by a brown rot basidiomycete. Environ. Microbiol. 2008, 10, 1844–1849. [Google Scholar] [CrossRef]
- Hori, C.; Gaskell, J.; Igarashi, K.; Samejima, M.; Hibbett, D.; Henrissat, B.; Cullen, D. Genomewide analysis of polysaccharides degrading enzymes in 11 white- and brown-rot Polyporales provides insight into mechanisms of wood decay. Mycologia 2013, 105, 1412–1427. [Google Scholar] [CrossRef]
- Martin, F.; Kohler, A.; Murat, C.; Veneault-Fourrey, C.; Hibbett, D.S. Unearthing the roots of ectomycorrhizal symbioses. Nat. Rev. Microbiol. 2016, 14, 760–773. [Google Scholar] [CrossRef]
- Rivera-Hoyos, C.M.; Morales-Alvarez, E.D.; Poutou-Pinales, R.A.; Pedroza-Rodriguez, A.M.; Rodriguez-Vazquez, R.; Del-gado-Boada, J.M. Fungal laccases. Fungal Biol. Rev. 2013, 27, 67–82. [Google Scholar] [CrossRef]
- Gong, W.; Wang, Y.; Xie, C.; Zhou, Y.; Zhu, Z.; Peng, Y. Whole genome sequence of an edible and medicinal mushroom, Hericium erinaceus (Basidiomycota, Fungi). Genomics 2020, 112, 2393–2399. [Google Scholar] [CrossRef] [PubMed]

| Parameter | Value |
|---|---|
| Gene assembly | |
| Contigs number | 50 |
| GC content (%) | 47.74 |
| N50 (bp) | 2,068,469 |
| N90 (bp) | 391,632 |
| Gene prediction and analysis | |
| Genome size (bp) | 40,153,731 |
| Number of protein-coding genes | 8705 |
| Gene total length (bp) | 18,498,255 |
| Gene average length (bp) | 2125.01 |
| CDSs total length (bp) | 12,578,619 |
| CDSs number | 62,798 |
| Exon length (bp) | 14,695,320 |
| Intron length (bp) | 3,802,935 |
| Repeated sequence percentage (%) | 38.52 |
| Non-coding RNA number | 107 |
| rRNA number | 11 |
| tRNA number | 78 |
| Pseudo gene number | 119 |
| Species | Total Gene Number | Total Gene Family Number | Cluster Gene Number |
|---|---|---|---|
| L. edodes | 9804 | 6136 | 7776 |
| F. velutipes | 14,460 | 7393 | 12,308 |
| P. ostreatus | 11,693 | 7333 | 10,130 |
| M. importuna | 11,971 | 6237 | 7649 |
| P. portentosus | 9899 | 6537 | 9104 |
| T. melanosporum | 7496 | 5503 | 5812 |
| B. edulis | 18,718 | 8153 | 15,426 |
| L. hatsudake | 16,831 | 8553 | 13,716 |
| L. deliciosus | 18,193 | 8772 | 14,583 |
| L. bicolor | 18,215 | 7721 | 13,863 |
| R. virescens | 20,499 | 7121 | 17,450 |
| R. griseocarnosa | 17,754 | 6593 | 15,618 |
| G. bonarii | 29,452 | 6309 | 25,493 |
| G. purpuraceus | 8705 | 6590 | 7875 |
| Secondary Metabolisms | Terpenes | NRPS and NRPS-like | PKS and PKS-like | DMAT | Siderophore | Hybrid | Other | Total |
|---|---|---|---|---|---|---|---|---|
| G. purpuraceus | 9 | 6 | 5 | 1 | 1 | 22 | ||
| G. bonarii | 14 | 3 | 2 | 19 | ||||
| R. griseocarnosa | 8 | 1 | 1 | 10 | ||||
| R. virescens | 9 | 1 | 2 | 12 | ||||
| L. bicolor | 9 | 4 | 3 | 1 | 17 | |||
| L. deliciosus | 18 | 2 | 2 | 22 | ||||
| L. hatsudake | 14 | 2 | 2 | 18 | ||||
| B. edulis | 8 | 9 | 2 | 1 | 20 | |||
| T. melanosporum | 0 | 4 | 4 | 8 | ||||
| P. portentosus | 7 | 7 | 3 | 3 | 20 | |||
| M. importuna | 1 | 6 | 3 | 10 | ||||
| P. ostreatus | 10 | 9 | 2 | 21 | ||||
| F. velutipes | 12 | 3 | 1 | 2 | 2 | 20 | ||
| L. edodes | 7 | 10 | 5 | 22 |
| Symbol and Definition | EC No. | KO Term | Gene ID |
|---|---|---|---|
| ACAT, acetyl-CoA C-acetyltransferase | EC:2.3.1.9 | K00626 | EVM0002057.1 |
| HMGCS, hydroxymethylglutaryl-CoA synthase | EC:2.3.3.10 | K01641 | EVM0008435.1 |
| HMGCR, hydroxymethylglutaryl-CoA reductase (NADPH) | EC:1.1.1.34 | K00021 | EVM0004540.1 |
| mvaK2, phosphomevalonate kinase | EC:2.7.4.2 | K00938 | EVM0000866.1 |
| mvaD, diphosphomevalonate decarboxylase | EC:4.1.1.33 | K01597 | EVM0000734.1 |
| IDI, isopentenyl-diphosphate Delta-isomerase | EC:5.3.3.2 | K01823 | EVM0005424.1 |
| FDPS, farnesyl diphosphate synthase | EC:2.5.1.1 2.5.1.10 | K00787 | EVM0002481.1 |
| GGPS1, geranylgeranyl diphosphate synthase, type III | EC:2.5.1.1 2.5.1.10 2.5.1.29 | K00804 | EVM0001739.1 |
| PCYOX1, prenylcysteine oxidase/farnesylcysteine lyase | EC:1.8.3.5 1.8.3.6 | K05906 | EVM0005178.1 |
| ICMT, protein-S-isoprenylcysteine O-methyltransferase | EC:2.1.1.100 | K00587 | EVM0004818.1 |
| STE24, STE24 endopeptidase | EC:3.4.24.84 | K06013 | EVM0003020.1 |
| RCE1, prenyl protein peptidase | EC:3.4.22.- | K08658 | EVM0006143.2 |
| FNTB, protein farnesyltransferase subunit β | EC:2.5.1.58 | K05954 | EVM0000741.3 |
| FNTA, protein farnesyltransferase/geranylgeranyltransferase type-1 subunit α | EC:2.5.1.58 2.5.1.59 | K05955 | EVM0000039.3 |
| DHDDS, ditrans, polycis-polyprenyl diphosphate synthase | EC:2.5.1.87 | K11778 | EVM0004045.1 |
| hexPS, hexaprenyl-diphosphate synthase | EC:2.5.1.82 2.5.1.83 | K05355 | EVM0005717.4 |
Publisher’s Note: MDPI stays neutral with regard to jurisdictional claims in published maps and institutional affiliations. |
© 2022 by the authors. Licensee MDPI, Basel, Switzerland. This article is an open access article distributed under the terms and conditions of the Creative Commons Attribution (CC BY) license (https://creativecommons.org/licenses/by/4.0/).
Share and Cite
Geng, Y.; Zhang, S.; Yang, N.; Qin, L. Whole-Genome Sequencing and Comparative Genomics Analysis of the Wild Edible Mushroom (Gomphus purpuraceus) Provide Insights into Its Potential Food Application and Artificial Domestication. Genes 2022, 13, 1628. https://doi.org/10.3390/genes13091628
Geng Y, Zhang S, Yang N, Qin L. Whole-Genome Sequencing and Comparative Genomics Analysis of the Wild Edible Mushroom (Gomphus purpuraceus) Provide Insights into Its Potential Food Application and Artificial Domestication. Genes. 2022; 13(9):1628. https://doi.org/10.3390/genes13091628
Chicago/Turabian StyleGeng, Yangyang, Shixin Zhang, Ningxian Yang, and Likang Qin. 2022. "Whole-Genome Sequencing and Comparative Genomics Analysis of the Wild Edible Mushroom (Gomphus purpuraceus) Provide Insights into Its Potential Food Application and Artificial Domestication" Genes 13, no. 9: 1628. https://doi.org/10.3390/genes13091628
APA StyleGeng, Y., Zhang, S., Yang, N., & Qin, L. (2022). Whole-Genome Sequencing and Comparative Genomics Analysis of the Wild Edible Mushroom (Gomphus purpuraceus) Provide Insights into Its Potential Food Application and Artificial Domestication. Genes, 13(9), 1628. https://doi.org/10.3390/genes13091628
